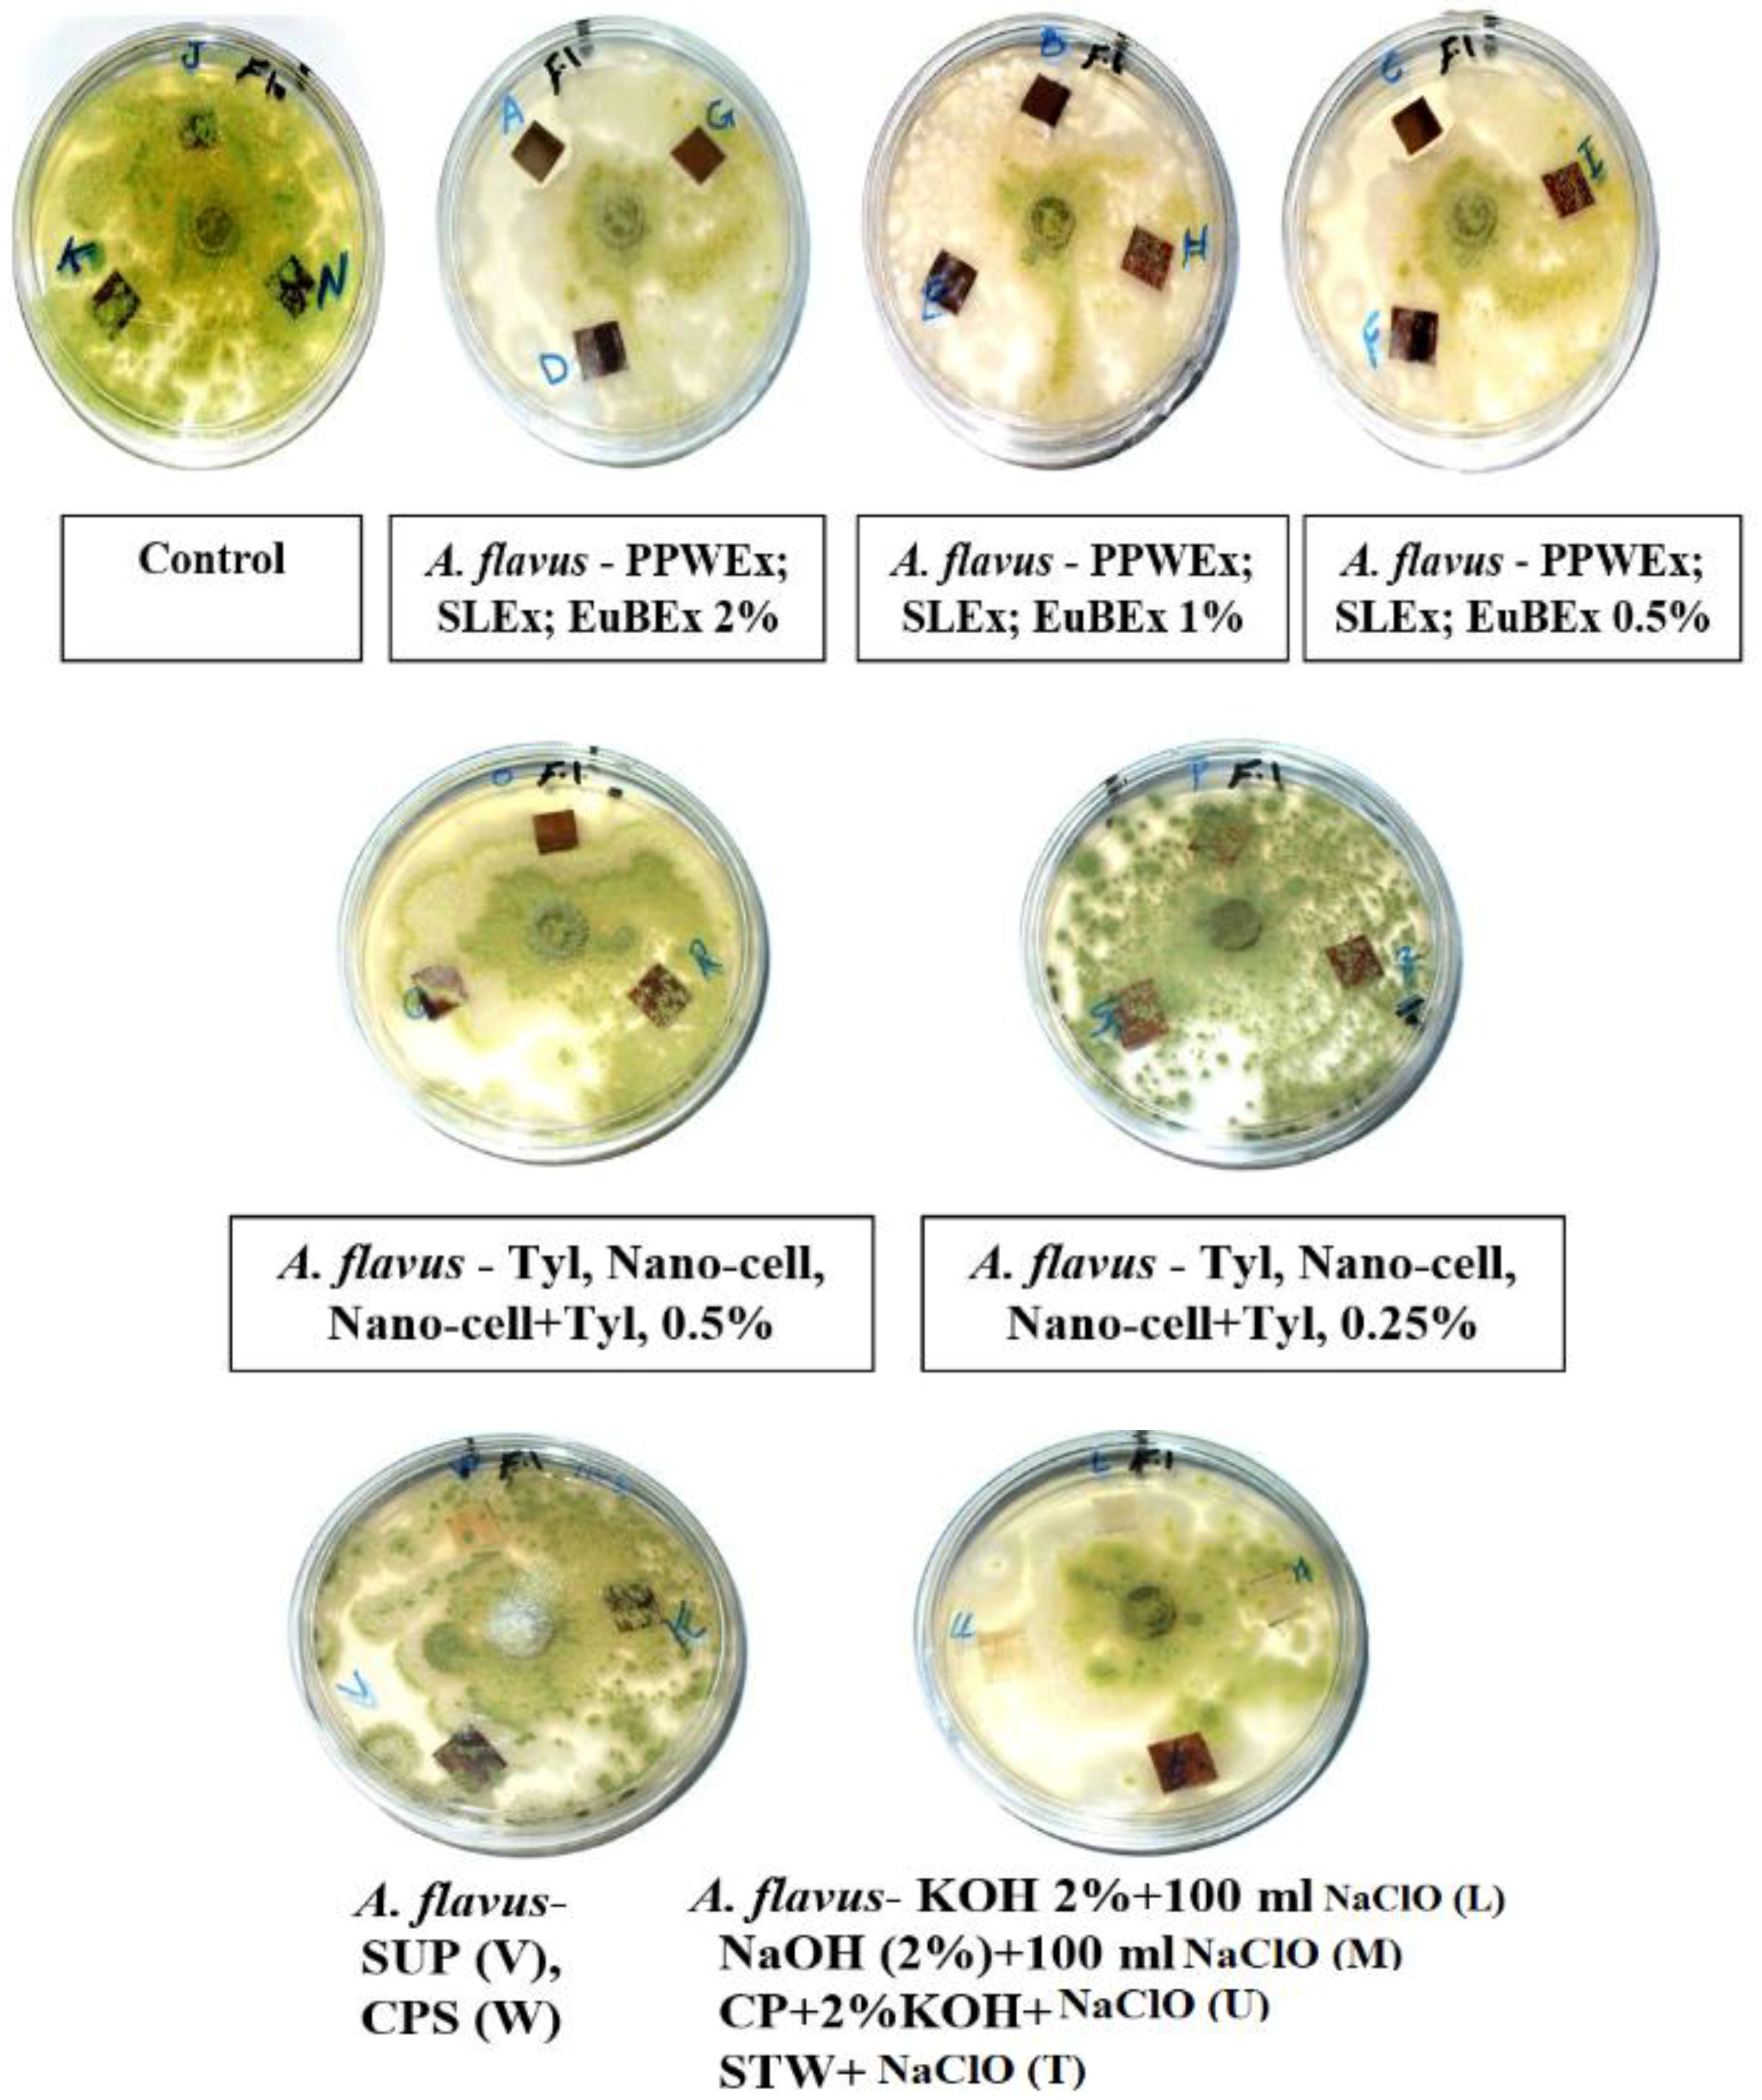
Materials 12 00620 g005

Assessment of the Impact of Different Treatments on the Technological and Antifungal Properties of Papyrus (Cyperus Papyrus L.) Sheets
Abstract
:1. Introduction
2. Materials and Methods
2.1. Chemicals Used
2.2. Preparation of Papyrus strips
2.3. Pre-Treatments of Papyrus strips
Preparation of Extracts and GC/MS Analysis
2.4. Testing of Papyrus Sheets
2.5. Antifungal Activity In Vitro
2.6. Scanning Electron Microscopy
- Some treatments reflect the effect of fungus on the fibres without any treatments and thus show the intensity of fungal growth and degree of resultant damage.
- Some of them reflect the highest concentration applied to the materials and thus clarify its effects on the growth of fungi.
- Shows the effect of the treatment solutions on the precise anatomy of the fibres treated with alkaline materials, such as sodium hydroxide, potassium hydroxide and bleach and illustrates the effect of these materials on the growth of fungi.
- Illustrates the effect of the different manufacturing stages (such as a hammering phase) on the degree of damage in the anatomical structure and the fungal growth on the manufactured samples.
- Shows the effect of the mixture treatments on the physical and biological properties of the manufactured papyrus sheets.
2.7. Statistical Analysis
3. Results and Discussions
3.1. Mechanical and Optical Properties
3.2. Visual Observations of the Antifungal Activity of Treated Papyrus Sheets
3.3. SEM Examination
4. Conclusions
Author Contributions
Funding
Acknowledgments
Conflicts of Interest
References
- Nicholson, P.T.; Shaw, I. Ancient Egyptian Materials and Technology. Cambridge University Press: Cambridge, UK, 2000; pp. 227–253. [Google Scholar]
- Lewis, N. Papyrus in Classical Antiquity; Oxford University Press: London, UK, 1974. [Google Scholar]
- Bridget, L.; Tait, J.W. Papyrus. Ancient Egyptian Materials and Technology; Nicholson, T.P., Shaw, I., Eds.; Cambridge University Press: Cambridge, UK, 2000; pp. 227–253. [Google Scholar]
- Afandy, A.H.; Eleasely, A.M. Some Experimental Results of Papyrus Physical Properties, J. King Saud Univ. Tour. Archaeol. 2012, 24, 1–7. [Google Scholar]
- Morrison, E.H.J.; Upton, C.; Pacini, N.; Odhiambo-K’oyooh, K.; Harper, D.M. Public perceptions of papyrus: Community appraisal of wetland ecosystem services at Lake Naivasha, Kenya. Ecohydrol. Hydrobiol. 2013, 13, 135–147. [Google Scholar] [CrossRef]
- Abdel-Maksoud, G.; El-Amin, A.-R. The investigation and conservation of a gazelle mummy from the late period in ancient Egypt. Med. Arhaeol. Archaeom. 2013, 13, 45–67. [Google Scholar]
- Gaudet, J. Papyrus, the Plant that Changed the World–From Ancient Egypt to Today’s Water Wars; Pegasus Books: New York, NY, USA, 2014. [Google Scholar]
- Jones, M.B.; Kansiime, F.; Saunders, M.J. The potential use of papyrus (Cyperus papyrus L.) wetlands as a source of biomass energy for Sub-Saharan Africa. GCB Bioenergy 2016, 10, 4–11. [Google Scholar] [CrossRef]
- Weidemann, H.G.; Bayer, G. Papyrus, the Paper of Ancient Egypt. Analyt. Chem. 1983, 55, 1220A–1230A. [Google Scholar] [CrossRef]
- Elnaggar, A.; Fitzsimons, P.; Nevin, A.; Watkins, K.; Strlič, M. Viability of lasereaning of papyrus: Conservation and scientific assessment. Stud. Conser. 2005, 60, S73–S81. [Google Scholar] [CrossRef]
- Menei, E.; Caylux, L. Strategy in the Case of a Wrecked Papyrus. Papierrestaurierung 2008, 9, 19–25. [Google Scholar]
- Ardelean, E.; Asandei, D.; Tanase, M.; Bobu, E. Study on some resizing and consolidation methods of old paper support. Eur. J. Sci. Theol. 2007, 3, 53–61. [Google Scholar]
- Ardelean, E.; Bobu, E.; Niculescu, Gh.; Groza, C. Effects of different consolidation additives on ageing behaviour of archived document paper. Cell. Chem. Technol. 2011, 45, 97–103. [Google Scholar]
- Rodrigues, J.D.; Grossi, A. Indicators and Ratings for the Compatibility Assessment of Conservation Actions. J. Cult. Herit. 2007, 8, 32–43. [Google Scholar] [CrossRef]
- Baker, C.A. Sodium Carboxymethylcellulose (SCMC) Re-evaluated for Paper, Book, Papyrus, and Parchment Conservation. Book Paper Group Ann. 2007, 26, 177–185. [Google Scholar]
- Timar, M.C.; Tuduce-Traistaru, A.; Porojan, M.; Gurau, L. An Investigation of Consolidants Penetration in Wood. Part 1: General Methodology and Microscopy. PRO LIGNO 2010, 6, 13–27. [Google Scholar]
- Walsh, Z.; Janeček, E.-R.; Jones, M.; Scherman, O.A. Natural polymers as alternative consolidants for the preservation of waterlogged archaeological wood. Stud. Conserv. 2015. [Google Scholar] [CrossRef]
- Menei, E.; Caylux, L. Strategy in the Case of a Wrecked Papyrus. Poster abstract; Paper Conservation: Decisions and Compromises; Extended Abstracts. In Proceedings of the ICOMCC Graphic Document Working Group Interim Meeting, Vienna, Austria, 17–19 April 2013. [Google Scholar]
- Bierbrier, M.L. Papyrus: Structure and Usage; British Museum Occasional Papers 60; Anne, M., Ed.; British Museum Press: London, UK, 1986. [Google Scholar]
- Darbre, F. The Papyrus Codex Tchacos: Its authentication, conservation and future. Papierrestaurierung 2008, 9, 19–25. [Google Scholar]
- EL-Hefny, M.; Ashmawy, N.A.; Salem, M.Z.M.; Salem, A.Z.M. Antibacterial activity of the phytochemicals-characterized extracts of Callistemon viminalis, Eucalyptus camaldulensis and Conyza dioscoridis against the growth of some phytopathogenic bacteria. Microb. Pathogen. 2017, 113, 348–356. [Google Scholar] [CrossRef]
- Salem, M.Z.M.; Zidan, Y.E.; Mansour, M.M.A.; El Hadidi, N.M.N.; Abo Elgat, W.A.A. Evaluation of usage three natural extracts applied to three commercial wood species against five common molds. Int. Biodeterior. Biodegr. 2016, 110, 206–226. [Google Scholar] [CrossRef]
- TAPPI Standards, T494 om-13. Tensile breaking properties of paper and paperboard; Technical Association of the Pulp and Paper Industrial: Atlanta, GA, USA, 2014. [Google Scholar]
- TAPPI Standards, T414 om-88. Internal Tearing Resistance of Paper; Technical Association of the Pulp and Paper Industrial: Atlanta, GA, USA, 2014. [Google Scholar]
- TAPPI Standards, T403 os-76. Bursting strength of paper; Technical Association of the Pulp and Paper Industrial: Atlanta, GA, USA, 2014. [Google Scholar]
- Gullichsen, J.; Paulapuro, H.; Stenius, P. Papermaking Science Technology; Fapet Oy, Book 4; Forest Products Chemistry: Helsinki, Finland, 2000; pp. 268–287. [Google Scholar]
- Reinprecht, L.; Kizlink, J. Wood preservatives prepared from electrical and cooling wastes. Acta Facultatis Ecologiae TU Zvolen 2007, 15, 71–76. [Google Scholar]
- Mansour, M.M.A.; Abdel-Megeed, A.; Nasser, R.A.; Salem, M.Z.M. Comparative evaluation of some woody trees methanolic extracts and Paraloid B-72 against phytopathogenic mold fungi Alternaria tenuissima and Fusarium culmorum. BioResources 2015, 10, 2570–2584. [Google Scholar] [CrossRef]
- SAS. User Guide: Statistics (Release 8.02); SAS Institute: Cary, NC, USA, 2001. [Google Scholar]
- Marrakchi, Z.; Khiari, R.; Oueslati, H.; Mauret, E.; Mhenni, F. Pulping and papermaking properties of Tunisian Alfa stems (Stipa tenacissima): Effects of refining process. Indust. Crop. Prod. 2011, 34, 1572–1582. [Google Scholar] [CrossRef]
- Anapanurak, W.; Laemsak, N.; Veenin, T.; Atiwannapat, P. Alkali-oxygen pulping on steam-explosion pretreated bamboo species. In Proceedings of the Production, Design and Industrial Aspects, VIII World Bamboo Congress, Bangkok, Thailand, 16–19 September 2009. [Google Scholar]
- Shatalov, A.A.; Pereira, H. Influence of stem morphology on pulp and paper properties of Arundo donax L. reed. Indus. Crop. Prod. 2002, 15, 77–83. [Google Scholar] [CrossRef]
- Barba, C.; Rosa, A.D.; Vidal, T.; Colom, J.F.; Farriol, X.; Montane, D. TCF bleached pulps from Miscanthus sinesis by the impregnation rapid steam pulping (IRSP) process. J. Wood Chem. Technol. 2002, 22, 249–266. [Google Scholar] [CrossRef]
- Finell, M.; Nilsson, C.; Olsson, R.; Agnemo, R.; Svensson, S. Briquetting of fractionated reed canary-grass for pulp production. Ind. Crop. Prod. 2002, 16, 185–192. [Google Scholar] [CrossRef]
- Law, K.N.; Kokta, B.V.; Mao, C.B. Fibre morphology and sodasulphite pulping of switchgrass. Bioresour. Technol. 2001, 77, 1–7. [Google Scholar] [CrossRef]
- Obi Reddy, K.; Uma Maheswari, C.; Shukla, M.; Muzenda, E. Preparation, chemical composition, characterization, and properties of Napier grass paper sheets. Sep. Sci. Technol. 2014, 49, 1527–1534. [Google Scholar] [CrossRef]
- Nasser, R.A.; Hiziroglu, S.; Abdel-Aal, M.A.; Al-Mefarrej, H.A.; Shetta, N.D.; Aref, I.M. Measurement of some properties of pulp and paper made from date palm midribs and wheat straw by soda-AQ pulping process. Measurement 2015, 62, 179–186. [Google Scholar] [CrossRef]
- Nassar, M.A.; Awad, H.M.; El-Sakhawy, M.; Hassan, Y.R. An optimum mixture of virgin rice straw pulp and recycled old Newsprint pulp and their antimicrobial activity. Int. J. Technol. 2015, 6, 63–72. [Google Scholar] [CrossRef]
- Salem, M.Z.M.; Ashmawy, N.A.; Elansary, H.O.; El-Settawy, A.A. Chemotyping of diverse Eucalyptus species grown in Egypt and antioxidant and antibacterial activities of its respective essential oils. Nat. Prod. Res. 2015, 29, 681–685. [Google Scholar] [CrossRef] [PubMed]
- Elansary, H.O.; Salem, M.Z.M.; Ashmawy, N.A.; Yessoufou, K.; El-Settawy, A.A. In vitro antibacterial, antifungal, and antioxidant activities of Eucalyptus spp. leaf extracts related to phenolic composition. Nat. Prod. Res. 2017, 31, 2927–2930. [Google Scholar] [CrossRef]
- Salem, A.Z.M.; Salem, M.Z.M.; Gonzalez-Ronquillo, M.; Camacho, L.M.; Cipriano, M. Major chemical constituents of Leucaena leucocephala and Salix babylonica leaf extracts. J. Trop. Agri. 2011, 49, 95–98. [Google Scholar]
- Shahidi Bonjar, G.H.; Aghighi, S.; Karimi, N.A. Antibacterial and antifungal survey in plants used in indigenous herbal-medicine of south east regions of Iran. J. Biol. Sci. 2004, 4, 405–412. [Google Scholar] [CrossRef]
- Farag Hanaa, R.M.; Abdou, Z.A.; Salam, D.A.; Ibrahim, M.A.R.; Sror, H.A.M. Effect of neem and willow aqueous extracts on fusarium wilt disease in tomato seedlings: Induction of antioxidant defensive enzymes. Ann. Agri. Sci. 2011, 56, 1–7. [Google Scholar]
- Roze, L.V.; Koptina, A.V.; Laivenieks, M.; Beaudry, R.M.; Jones, D.A.; Kanarsky, A.V.; Linz, J.E. Willow volatiles influence growth, development, and secondary metabolism in Aspergillus parasiticus. Appl. Microbiol. Biotechnol. 2011, 92, 359–370. [Google Scholar] [CrossRef] [PubMed]
- Ghasemi, S.; Abbasi, S.; Bahraminejad, S.; Harighi, B. Inhibitory effect of some plant crude extracts against cucumber damping-off agents. Australasian Plant Pathol. 2012, 41, 331–338. [Google Scholar] [CrossRef]
- Abdel-Kareem, O.M.A. Microbiological testing of Polymers and resins used in conservation of Linen Textiles. In Proceedings of the 15th World Conference on Nondestructive Testing, Roma, Italy, 15–21 October 2000. with Exhibition. [Google Scholar]
- Cataldi, A.; Berglund, L.; Deflorian, F.; Pegoretti, A. A comparison between micro–and nanocellulose-filled composite adhesives for oil paintings restoration. Nanocomposites 2015, 18, 1–9. [Google Scholar] [CrossRef]
- Abdel-Kareem, O.M.A. Microbiological Studies to Evaluate Polymers and Resins Used in Consolidation of Ancient Egyptian Linen Textiles. Czas. Tech. 2000, 1, 202–211. [Google Scholar]

| Treatment | Code | Strips Pre-Treatment | Abbreviation |
|---|---|---|---|
| T1 | A | Treated with Pitch pine wood extract (2%) | PPWEx 2% |
| T2 | B | Treated with Pitch pine wood extract (1%) | PPWEx 1% |
| T3 | C | Treated with Pitch pine wood extract (0.5%) | PPWEx 0.5% |
| T4 | D | Treated with Salix babylonica leaf extract (2%) | SLEx 2% |
| T5 | E | Treated with S. babylonica leaf extract (1%) | SLEx 1% |
| T6 | F | Treated with S. babylonica leaf extract (0.5%) | SLEx 0.5% |
| T7 | G | Treated with Eucalyptus camaldulensis bark extract (2%) | EuBEx 2% |
| T8 | H | Treated with E. camaldulensis bark extract (1%) | EuBEx 1% |
| T9 | I | Treated with E. camaldulensis bark extract (0.5%) | EuBEx 0.5% |
| T10 | J | Treated with 10% of dimethyl sulfoxide | DMSO 10% (control) |
| T11 | K | Soaked in tap water after hammering | STWC (control) |
| T12 | L | Treated with KOH (2%) + 100 mL NaClO for 1 h | KOH 2% + 100 mL NaClO |
| T13 | M | Treated with NaOH (2%) + 100 mL NaClO for 1 h | NaOH (2%) + 100 mL NaClO |
| T14 | N | Soaking in distilled water without hammering | SDW (control) |
| T15 | O | Treated with tylose (0.5%) diluted in ethanol 95% and water | Tyl 0.5% |
| T16 | P | Treated with tylose (0.25%) diluted in ethanol 95% and water | Tyl 0.25% |
| T17 | Q | Treated with nano-cellulose 0.5% + Tylose 0.5% (1:1 v/v) | Nano-cell + Tyl 0.5% (1:1 v/v) |
| T18 | q | Treated with mixture of nano-cellulose 0.25% + Tylose 0.25% (1:1 v/v) | Nano-cell + Tyl 0.25% (1:1 v/v) |
| T19 | R | Treated with nano-cellulose (0.5%) dissolved in ethanol 95% | Nano-cell 0.5% |
| T20 | S | Treated with nano-cellulose (0.25%) dissolved in ethanol 95% | Nano-cell 0.25% |
| T21 | T | Soaked in tap water then chlorinated (100 mL NaClO) for 1 h | STW + 100 mL NaClO |
| T22 | U | Hammered Papyrus sheets soaked in 2% KOH then chlorinated (100 mL NaClO) for 1 h and cold pressed | CP+2%KOH + 100 mL NaClO. |
| T23 | V | Soaked un-hammered Papyrus sheets for 1 week in tap water then cold pressed without any treatments. | SUP (control) |
| T24 | W | Commercial Papyrus sheets (hammered + KOH + Chlorination) | CPS (control) |
| Strips Pre-Treatment | Tensile | Tear | Burst | Fold | Brightness | Darkness | Grammage |
|---|---|---|---|---|---|---|---|
| N·m/g | mN·m2/g | kpa·m2/g | N | % | % | (g/m2) | |
| PPWEx 2% | 82.4 k ± 0.10 | 2123.33 h ± 0.57 | 568.33 n ± 0.58 | 3.66 defg ± 0.57 | 13.33 j ± 0.05 | 97.8 f ± 0.10 | 157.41 fg ± 6.41 |
| PPWEx 1% | 87.9 e ± 0.78 | 2232 c ± 1.73 | 785.33 f ± 1.53 | 4.33 cde ± 0.57 | 14.23 i ± 0.05 | 99.46 c ± 0.15 | 220 b ± 6.66 |
| PPWEx 0.5% | 83.4 j ± 0.20 | 2146.33 g ± 1.52 | 574 m ± 1 | 3.66 defg ± 0.57 | 14.2 i ± 0.1 | 99.76 ab ± 0.06 | 183.33 c ± 4.12 |
| SLEx 2% | 85.33 h ± 0.06 | 2197.33 e ± 1.15 | 683.33 i ± 3.05 | 4.33 cde ± 0.57 | 12.36 k ± 0.05 | 99.86 a ± 0.06 | 148.15 hi ± 3.21 |
| SLEx 1% | 84.6 i ± 0.10 | 2195.67 e ± 0.57 | 654.33 k ± 1.52 | 4 cdef ± 1 | 16.5 f ± 0.1 | 99.06 d ± 0.41 | 172.22 de ± 5.55 |
| SLEx 0.5% | 86.73 g ± 0.23 | 2212.33 d ± 0.57 | 774.33 g ± 0.57 | 4.66 cd ± 1.15 | 12.13 l ± 0.15 | 99.76 ab ± 0.06 | 165.43 ef ± 4.27 |
| EuBEx 2% | 81.33 l ± 0.06 | 2019 i ± 11.26 | 521 p ± 1 | 3 fgh ± 1 | 9.6 o ± 0.1 | 99.7 ab ± 0.10 | 157.57 fg ± 6.06 |
| EuBEx 1% | 88.66 d ± 0.06 | 1981.67 k ± 1.53 | 443 q ± 1 | 4 cdef ± 1 | 11.63 m ± 0.05 | 99.8 a ± 0.10 | 144 hi ± 0.00 |
| EuBEx 0.5% | 86.50 g ± 0.00 | 2174.33 f ± 11.01 | 647.67 l ± 0.57 | 5 c ± 1 | 11.53 m ± 0.05 | 99.86 a ± 0.06 | 141.56 i ± 2.85 |
| DMSO 10% (control) | 77.70 o ± 0.10 | 2343.67 a ± 0.57 | 787.33 e ± 1.15 | 3.33 efgh ± 0.57 | 11.56 m ± 0.05 | 98.76 e ± 0.06 | 128.21 j ± 3.17 |
| STWC (control) | 78.66 n ± 0.06 | 2234.33 c ± 0.57 | 666.33 j ± 1.15 | 4.33 cde ± 0.57 | 9.5 o ± 0.10 | 99.6 bc ± 0.10 | 191.14 c ± 4.03 |
| KOH 2% + 100 mL NaClO | 43.33 r ± 0.11 | 910.67 o ± 1.15 | 196.67 v ± 0.57 | 1.66 i ± 0.57 | 49.7 a ± 0.10 | 62.53 m ± 0.05 | 82.25 m ± 9.92 |
| NaOH (2%) + 100 mL NaClO | 55.16 q ± 0.21 | 871 p ± 1 | 312.67 u ± 1.15 | 2.33 hi ± 0.57 | 40.1 b ± 0.10 | 67.26 l ± 0.06 | 94.25 l ± 3.98 |
| SDW (control) | 80.23 m ± 0.06 | 1961.67 l ± 1.53 | 523.67 o ± 0.58 | 3.66 defg ± 0.57 | 14.3 i ± 0.26 | 97.66 f ± 0.11 | 174.59 d ± 0.40 |
| Tyl 0.5% | 87.56 f ± 0.06 | 2233 c ± 1 | 833.33 b ± 0.58 | 4.33 cde ± 0.57 | 13.36 j ± 0.15 | 95.56 h ± 0.06 | 368.88 a ± 7.69 |
| Tyl 0.25% | 89.76 c ± 0.06 | 2241.33 b ± 1.53 | 1162 a ± 1 | 4.66 cd ± 0.57 | 15.5 g ± 0.10 | 96.66 g ± 0.06 | 173.81 d ± 4.12 |
| Nano-cell + Tyl 0.5% (1:1 v/v) | 83.53 j ± 0.06 | 2211.67 d ± 1.53 | 795.33 d ± 0.58 | 4.66 cd ± 0.57 | 12.16 l ± 0.15 | 90.6 j ± 0.10 | 151.51 gh ± 6.06 |
| Nano-cell + Tyl 0.25% (1:1 v/v) | 83.46 j ± 0.06 | 2210.67 d ± 0.58 | 794.67 d ± 0.58 | 4.66 cd ± 0.57 | 12.1 l ± 0.10 | 90.6 j ± 0.10 | 129.29 j ± 3.49 |
| Nano-cell 0.5% | 98.66 a ± 0.06 | 2230.67 c ± 0.58 | 817 c ± 1 | 8.33 a ± 0.57 | 15.56 g ± 0.06 | 99.2 d ± 0.10 | 174.67 d ± 2.77 |
| Nano-cell 0.25% | 98.90 a ± 0.10 | 1873.67 m ± 1.53 | 723.33 h ± 0.58 | 3.66 defg ± 0.57 | 14.53 h ± 0.06 | 97.76 f ± 0.06 | 186.14 c ± 3.75 |
| STW + NaClO | 98.63 a ± 0.06 | 1587 n ± 1 | 320 t ± 1 | 7.33 ab ± 0.57 | 27.86 c ± 0.06 | 99.8 a ± 0.10 | 169.42 de ± 1.73 |
| CP + 2%KOH + NaClO | 93.26 b ± 0.23 | 1997 j ± 1 | 365.33 s ± 0.58 | 6.66 b ± 0.57 | 26.4 d ± 0.10 | 72.73 k ± 0.06 | 103.48 k ± 1.88 |
| SUP (control) | 89.73 c ± 0.06 | 1996.67 j ± 0.58 | 772.67 g ± 0.58 | 6.33 b ± 0.57 | 11.3 n ± 0.10 | 98.63 e ± 0.06 | 156.25 g ± 6.25 |
| CPS (control) | 60.40 p ± 0.10 | 807.67 q ± 0.58 | 388 r ± 1 | 2.66 ghi ± 0.57 | 25.43 e ± 0.06 | 95.13 i ± 0.11 | 151.85 gh ± 6.41 |
| LSD0.05 | 0.325 | 5.557 | 1.794 | 1.144 | 0.175 | 0.196 | 8.08 |
| Treatment | Code | A. flavus | C. gloeosporioides | A. niger | |||||||||
|---|---|---|---|---|---|---|---|---|---|---|---|---|---|
| Growth on Disc (mm) | Inhibition Zone (mm) * | Growth on Disc (mm) | Inhibition Zone (mm) * | Growth on Disc (mm) | Inhibition Zone (mm) * | ||||||||
| 7th day | 14th day | 7th day | 14th day | 7th day | 14th day | 7th day | 14th day | 7th day | 14th day | 7th day | 14th day | ||
| PPWEx 2% | A | 7–8 | 5–7 | 0 | 0 | 5–8 | 5–6 | 0 | 0 | 5–9 | 3–8 | 0 | 0 |
| PPWEx 1% | B | 2–4 | 1–2 | 0 | 0 | 3–5 | 0–2 | 0 | 1–2 | 0–1 | 0 | 1–5 | 5–8 |
| PPWEx 0.5% | C | 2–3 | 1–3 | 0 | 0 | 3–4 | 1–2 | 0 | 0–1 | 0–1 | 0 | 2–5 | 6–10 |
| SLEx 2% | D | 1–3 | 0–3 | 0 | 0–2 | 4–6 | 2–4 | 0 | 0 | 1–3 | 0–2 | 0–1 | 0–4 |
| SLEx 1% | E | 1–2 | 0–2 | 0 | 0–2 | 2–3 | 0–1 | 0 | 1–2 | 0 | 0 | 5–8 | 10 |
| SLEx 0.5% | F | 1–2 | 0–1 | 0–2 | 1–2 | 2–3 | 0–2 | 0 | 0 | 0 | 0 | 6–8 | 10 |
| EuBEx 2% | G | 2–3 | 1–2 | 0 | 0–1 | 2–4 | 1–3 | 0 | 0–1 | 1–2 | 0–1 | 0–2 | 1–5 |
| EuBEx 1% | H | 1–2 | 0–1 | 0–1 | 3–4 | 2–4 | 1–4 | 0 | 0 | 0 | 0 | 3–5 | 10 |
| EuBEx 0.5% | I | 0–1 | 0 | 1–2 | 5–7 | 1–2 | 0–2 | 0–1 | 1–3 | 0 | 0 | 4–7 | 10 |
| DMSO 10% | J | 0 | 0 | 2–5 | 8–10 | 0 | 0 | 0–1 | 3–8 | 0 | 0 | 5–7 | 10 |
| STWC | K | 0 | 0 | 1–2 | 9–10 | 0 | 0 | 0–2 | 3–9 | 0 | 0 | 3–5 | 10 |
| KOH 2% +100 mL NaClO | L | 0 | 0–1 | 0 | 0–1 | 0 | 0 | 0–1 | 1–2 | 0–5 | 0–2 | 0–1 | 1–2 |
| NaOH (2%) + 100 mL NaClO | M | 0 | 0 | 3–5 | 5 | 0 | 0 | 0–2 | 1–3 | 0 | 0 | 2–4 | 3–5 |
| SDW | N | 0 | 0 | 5–10 | 7–10 | 1-3 | 0 | 0–1 | 2–8 | 0 | 0 | 5–8 | 10 |
| Tyl 0.5% | O | 1–2 | 0 | 0–7 | 0–8 | 0 | 0 | 1–5 | 2–5 | 1–7 | 1–5 | 0 | 0 |
| Tyl 0.25% | P | 0 | 0 | 3–5 | 8–10 | 0 | 0 | 0–2 | 0–3 | 0–2 | 0–1 | 0–1 | 0–1 |
| Nano-cell + Tyl 0.5% (1:1 v/v) | Q | 0 | 0 | 3–6 | 6–8 | 0 | 0 | 0–1 | 0–1 | 1–4 | 1–3 | 0 | 0 |
| Nano-cell + Tyl 0.25% (1:1 v/v) | q | 0 | 0 | 10 | 10 | 0 | 0 | 0–2 | 0–2 | 0–2 | 0–1 | 0 | 0–2 |
| Nano-cell 0.5% | R | 0 | 0 | 5–8 | 7–10 | 0 | 0 | 1–2 | 1–2 | 0 | 0 | 1–2 | 1–4 |
| Nano-cell 0.25% | S | 0–3 | 0 | 0–6 | 2–8 | 0 | 0 | 1–3 | 2–3 | 0 | 0 | 0–2 | 1–5 |
| STW + NaClO | T | 0 | 0 | 0–3 | 1–9 | 0 | 0 | 0–1 | 1–2 | 0–5 | 0–1 | 0–1 | 0–2 |
| CP + 2%KOH + NaClO | U | 1–2 | 0 | 0 | 0–1 | 0 | 0 | 0 | 0–1 | 0–2 | 0 | 0–4 | 8–10 |
| SUP | V | 0 | 0 | 1–5 | 9–10 | 0 | 0 | 0–2 | 1–3 | 0–2 | 0–1 | 0–2 | 0–4 |
| CPS | W | 0 | 0 | 0–5 | 4–10 | 0 | 0 | 0–1 | 1–2 | 0–2 | 0 | 0–4 | 5–8 |
| Extract | Main Chemical Compounds |
|---|---|
| E. camaldulensis bark extract | oleic acid (12.99%), oleic acid, hexyl ester (12.13%), 9-hexadecenoic acid (9.08%), 2-(acetyloxy)-1-[(acetyloxy)methyl]ethyl (9E,12E,15E)-9,12,15-octadecatrienoate (7.50%), (Z,Z)-9,12-octadecadienoic acid (5.79%), digitoxin (4.88%), 1,1-bis(dodecyloxy)hexadecane (3.50%), 9-octadecensaeure (3.36%), (Z,Z)-1,3-dioctadecenoyl glycerol (3.28%) and 2-(12-pentadecynyloxy)tetrahydro-2H-pyran (3.18%). |
| P. rigida heartwood * | α-terpineol (24.91%), borneol (10.95%), terpin hydrate (9.60%), D-fenchyl alcohol (5.99%), 2-pinen-4-ol (4.18%), 8-hydroxycarvotanacetone (2.62%), exo-2-hydroxycineole (2.45%), epoxylinalol (2.35%), oleic acid (2.29%) and carvone hydrate (2.09%). |
| Salix babylonica leaf extract | Z-8-methyl-9-tetradecenoic acid (8.74%), (Z)-9-octadecenoic acid (6.63%), 9-hexadecenoic acid (5.57%), 1,6-dihydrocarveol (3.35%), 3-[2-phenylethenyl]cholestan-2-one (2.26%), 2,6-dioxatricyclo[3.3.2.0(3,7)]decan-9-ol (2.06%), 9,12,15-octadecatrienoic acid, methyl ester (1.62%), 9,12-octadecadienoic acid (Z,Z)–(1.59%), 4α-phorbol 12,13-didecanoate (1.45%), tetrahydro-α,α,5-trimethyl-5-vinyl-furfuryl alcohol (1.24%), pentaneundecanoic acid (1.12%), 7-hydroxy-6-methyl-oct-3-enoic acid (1.03%), E-7-tetradecenol (1.01%), Z,Z,Z-1,4,6,9-nonadecatetraene (0.92%), (all-Z)-5,8,11,14-eicosatetraenoic acid, methyl ester (0.92%), 25-norisopropyl-9,19-cyclolanostan-22-en-24-one, 3-acetoxy-24-phenyl-4,4,14-trimethyl–(0.79%), (5α,17β)-androstan-3-one-17-methoxy-3-methoxime (0.63%) and 3-acetoxy-7,8-epoxylanostan-11-ol (0.40%). |
© 2019 by the authors. Licensee MDPI, Basel, Switzerland. This article is an open access article distributed under the terms and conditions of the Creative Commons Attribution (CC BY) license (http://creativecommons.org/licenses/by/4.0/).
Share and Cite
Taha, A.S.; Salem, M.Z.M.; Abo Elgat, W.A.A.; Ali, H.M.; Hatamleh, A.A.; Abdel-Salam, E.M. Assessment of the Impact of Different Treatments on the Technological and Antifungal Properties of Papyrus (Cyperus Papyrus L.) Sheets. Materials 2019, 12, 620. https://doi.org/10.3390/ma12040620
Taha AS, Salem MZM, Abo Elgat WAA, Ali HM, Hatamleh AA, Abdel-Salam EM. Assessment of the Impact of Different Treatments on the Technological and Antifungal Properties of Papyrus (Cyperus Papyrus L.) Sheets. Materials. 2019; 12(4):620. https://doi.org/10.3390/ma12040620
Chicago/Turabian StyleTaha, Ayman S., Mohamed Z. M. Salem, Wael A. A. Abo Elgat, Hayssam M. Ali, Ashraf A. Hatamleh, and Eslam M. Abdel-Salam. 2019. "Assessment of the Impact of Different Treatments on the Technological and Antifungal Properties of Papyrus (Cyperus Papyrus L.) Sheets" Materials 12, no. 4: 620. https://doi.org/10.3390/ma12040620










